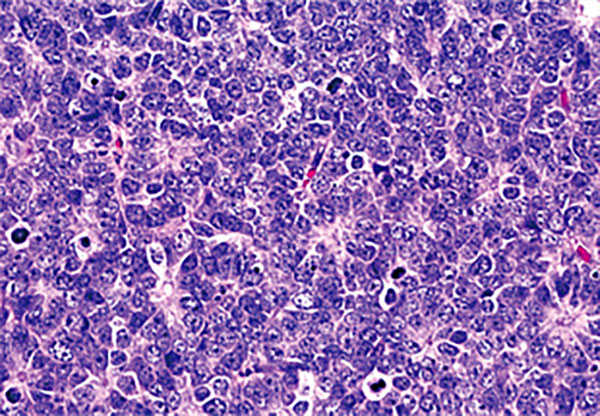
膵NEC

病理組織学的分類(WHO分類)は、腫瘍の性質とその予後を見きわめ、治療方針を決めるうえで重要な分類となります。また、発生する臓器により分類が異なり、現在は膵・消化管(表1)、肺(表2)の2つの分類がそれぞれ用いられております。
膵・消化管NETの場合
NETとNECは、腫瘍細胞がどれだけ増殖をしているのかという事を正確に判定するために、核分裂の過程にある細胞数がどのくらいあるのかという事を検討する“核分裂像数”と、増殖している細胞すべてで発現している核抗原を免疫組織化学的に同定して増殖している細胞数の割合を求める“Ki-67指数”を用いて確定診断されます(表1)。日本では主にKi-67指数を用います。
肺NENの場合
肺NETでは、細胞の形からカルチノイドと神経内分泌癌の2つに大きく分けられます。さらに、カルチノイドは定型カルチノイドと異型カルチノイドに、神経内分泌癌は小細胞癌と大細胞神経内分泌癌の4つに分けられます。分類を確実にするため、Ki-67指数や神経内分泌マーカー(シナプトフィジンやクロモグラニンA)の検査も実施されます(表2)。
また、患者さんの腫瘍がどの程度進んでいるかをあらわすには病期(ステージ)というものが使われます。腫瘍ができた臓器によって、それぞれの基準で、IからIV期の4段階に大きく分類されます。ステージを決めるときにはTNM分類と呼ばれる、腫瘍の大きさ(T因子)、周辺のリンパ節への転移の有無(N因子)、別の臓器への転移の有無(M因子)の3つの要素を組み合わせた分類が用いられます。IV期に近いほどがんが広がっている状態(進行がん)です。NETでも他の癌腫同様このTNM分類が設定されており、予後予測を行う上で必要なものと考えられております。詳しくは担当の医師にお問い合わせください。
表1:膵・消化管のWHO分類2019
分類/グレード | Ki-67指数 | 核分裂像数(/10HPF) | 特徴 |
---|---|---|---|
高分化型:NET G1 | <3% | <2 | 高分化型 腫瘍細胞は、腫瘍細胞は正常の細胞に似ている 増殖能は低く、低~中悪性度 カルチノイド腫瘍と呼ばれる場合もある |
高分化型:NET G2 | 3~20% | 2~20 | 高分化型 腫瘍細胞は、腫瘍細胞は正常の細胞に似ている 増殖能は低く、低~中悪性度 カルチノイド腫瘍と呼ばれる場合もある |
高分化型:NET G3 | >20% | >20 | 高分化型 腫瘍細胞は、腫瘍細胞は正常の細胞に似ている 増殖能は低く、低~中悪性度 カルチノイド腫瘍と呼ばれる場合もある |
低分化型:NEC(G3) 小細胞型、大細胞型 |
>20% | >20 | 低分化型 腫瘍細胞は正常細胞の機能をほとんど持たず、未熟で、増殖能が高い 増殖能は高く、高悪性度 小細胞癌、大細胞癌に分けられる |
表2:肺のWHO分類2021
細胞形態 | 核分裂像数 | 壊死 | |
---|---|---|---|
カルチノイド:定型カルチノイド | 5mm以上のカルチノイド形態 | <2 | なし |
カルチノイド:異型カルチノイド | カルチノイド形態 | 2~10 | あり(限局性で点状) |
神経内分泌癌:小細胞癌 | 小型で(通常小リンパ球3つ分の直径以下)、細胞質が乏しい、微細顆粒状のクロマチン、核小体がないまたは目立たない | >10 | あり(しばしば広範) |
神経内分泌癌:大細胞神経 内分泌癌 |
神経内分泌形態(類器官様胞巣、柵状、ロゼット形成、索様)、大型で非小細胞癌の特徴を示す(低いN/C比、水泡様核、疎もしくは微細なクロマチン、しばしば核小体を伴う)、クロマチンは粗造から顆粒状、Ki-67標識率>30%、NSE以外1つ以上の神経内分泌マーカー陽性または神経内分泌顆粒を確認 | ≧11 | あり(しばしば広範) |
補足:肺NETは神経内分泌癌とカルチノイドの性質の差が大きいなどの理由から、“カルチノイド”という名称が使われています。
NEN病理組診断に用いられる因子
組織学的分化度(腫瘍細胞の性質)
一般的に、高分化の腫瘍(発生組織の正常細胞に似ているもの)NETは比較的性質がよく、臨床的にはおとなしく、逆に低分化の腫瘍(正常細胞の機能をほとんど持たず、未熟なもの)NECは悪性度が高く、その治療が難しいといわれています。
腫瘍の増殖能力
“核分裂像数”と“Ki-67指数”は、細胞分裂の程度を示すマーカーです。これらの数値が高いと、一般的には腫瘍細胞の増殖が速く、悪性度も高いと考えられています。
腫瘍の大きさ(T因子)
腫瘍の大きさと浸潤(腫瘍が周囲の臓器に入り込むこと)を示します。
リンパ節転移(N因子)
周辺のリンパ節への転移があることを示します。
転移(M因子)
他の臓器に転移がある場合や浸潤していることを示します。
NETとNECの病理組織像の違い

膵NET
比較的均一な円形の核を有する腫瘍細胞が規則正しく配列、増殖しています。
笹野先生よりご提供
-
WHO Classification of Tumours of Endocrine Organs. Eds: Lloyd RV, et al. 4th Edition, 2017 IARC Press, Lyon France.
-
WHO Classification of Tumours. Digestive System Tumours. Eds: WHO Classification of Tumours Editorial Board. 5th Edition, 2019, IARC, Lyon, France.より作表
-
WHO 第5版に基づく胸部腫瘍組織分類-v1.3.pdf (haigan.gr.jp) より作表
-
WHO Classification of Tumours of the Digestive System Eds: Bosman FT, et al. 4th Edition, 2010 IARC Press, Lyons France